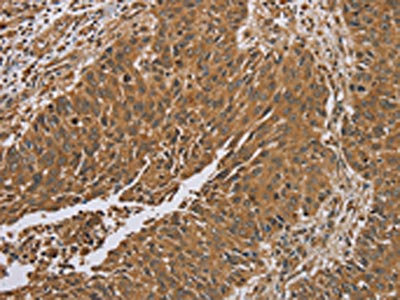

RAB8A Antibody
-
中文名稱:RAB8A兔多克隆抗體
-
貨號:CSB-PA790236
-
規格:¥1100
-
圖片:
-
The image on the left is immunohistochemistry of paraffin-embedded Human liver cancer tissue using CSB-PA790236(RAB8A Antibody) at dilution 1/45, on the right is treated with synthetic peptide. (Original magnification: ×200)
-
The image on the left is immunohistochemistry of paraffin-embedded Human lung cancer tissue using CSB-PA790236(RAB8A Antibody) at dilution 1/45, on the right is treated with synthetic peptide. (Original magnification: ×200)
-
Gel: 6%SDS-PAGE,Lysate: 40 μg,,Primary antibody: CSB-PA790236(RAB8A Antibody) at dilution 1/200 dilution,Secondary antibody: Goat anti rabbit IgG at 1/8000 dilution,Exposure time: 40 seconds
-
-
其他:
產品詳情
-
Uniprot No.:
-
基因名:
-
別名:AA409338 antibody; MEL antibody; Mel transforming oncogene (derived from cell line NK14) RAB8 homolog antibody; Mel transforming oncogene (derived from cell line NK14) antibody; Mel transforming oncogene (RAB8 homolog) antibody; Mel transforming oncogene antibody; MGC124948 antibody; Oncogene c mel antibody; Oncogene c-mel antibody; RAB8 antibody; RAB8A antibody; RAB8A member RAS oncogene family antibody; RAB8A_HUMAN antibody; Ras associated protein RAB8 antibody; Ras related protein Rab 8A antibody; Ras-related protein Rab-8A antibody
-
宿主:Rabbit
-
反應種屬:Human,Mouse,Rat
-
免疫原:Synthetic peptide of Human RAB8A
-
免疫原種屬:Homo sapiens (Human)
-
標記方式:Non-conjugated
-
抗體亞型:IgG
-
純化方式:Antigen affinity purification
-
濃度:It differs from different batches. Please contact us to confirm it.
-
保存緩沖液:-20°C, pH7.4 PBS, 0.05% NaN3, 40% Glycerol
-
產品提供形式:Liquid
-
應用范圍:ELISA,WB,IHC
-
推薦稀釋比:
Application Recommended Dilution ELISA 1:1000-1:2000 WB 1:200-1:1000 IHC 1:50-1:300 -
Protocols:
-
儲存條件:Upon receipt, store at -20°C or -80°C. Avoid repeated freeze.
-
貨期:Basically, we can dispatch the products out in 1-3 working days after receiving your orders. Delivery time maybe differs from different purchasing way or location, please kindly consult your local distributors for specific delivery time.
-
用途:For Research Use Only. Not for use in diagnostic or therapeutic procedures.
相關產品
靶點詳情
-
功能:The small GTPases Rab are key regulators of intracellular membrane trafficking, from the formation of transport vesicles to their fusion with membranes. Rabs cycle between an inactive GDP-bound form and an active GTP-bound form that is able to recruit to membranes different sets of downstream effectors directly responsible for vesicle formation, movement, tethering and fusion. That Rab is involved in polarized vesicular trafficking and neurotransmitter release. Together with RAB11A, RAB3IP, the exocyst complex, PARD3, PRKCI, ANXA2, CDC42 and DNMBP promotes transcytosis of PODXL to the apical membrane initiation sites (AMIS), apical surface formation and lumenogenesis. Together with MYO5B and RAB11A participates in epithelial cell polarization. May be involved in ciliogenesis. Together with MICALL2, may also regulate adherens junction assembly. May play a role in insulin-induced transport to the plasma membrane of the glucose transporter GLUT4 and therefore play a role in glucose homeostasis. Involved in autophagy.
-
基因功能參考文獻:
- Our findings reveal a new function of LRRK2 mediated by Rab8a phosphorylation and related to various centrosomal defects. PMID: 29357897
- Rab8a is phosphorylated by LRRK2.Phosphorylation of Rab8a plays important role in the fusion and enlargement of lipid droplets. PMID: 29482628
- C9ORF72 causes suboptimal autophagy PMID: 27494456
- GRAF1-mediated removal of Rab8 from the cell surface restricts its activity during protrusion formation, thereby facilitating dynamic adjustment of the polarity axis. PMID: 28137756
- Ectopic expression of an N-terminal-truncated ARHGEF10 mutant led to the generation of large vesicle-like structures containing both Rab6 and Rab8. PMID: 27550519
- report the design of a bioavailable StRIP3 analogue that harbors two hydrophobic cross-links and exhibits increased binding affinity, combined with robust cellular uptake and extremely high proteolytic stability. Localization experiments reveal that this double-stapled peptide and its target protein Rab8a accumulate in the same cellular compartments PMID: 27336832
- knockdown of another Parkinson's disease (PD) gene, LRRK2, which phosphorylates Rab8a, similarly impairs retromer trafficking, secretory autophagy and Golgi-derived vesicle secretion, thus demonstrating converging roles of two PD genes TMEM230 and LRRK2 on Rab8a function, and suggesting that retromer and secretory dysfunction play an important role in PD pathogenesis. PMID: 28115417
- Rab8 can induce Rac1- and Tiam1-dependent cortical actin polymerization and focal adhesion disassembly through the proteases MT1-MMP and calpain, and Rho-GTPase-dependent mechanisms PMID: 26940916
- Data demonstrate that EHBP1L1 links Rab8 and the Bin1-dynamin complex, which generates membrane curvature and excises the vesicle at the endocytic recycling compartment for apical transport. PMID: 26833786
- Further exploration of the NINL-associated interactome identifies MICAL3, a protein known to interact with Rab8 and to play an important role in vesicle docking and fusion. PMID: 26485645
- The small GTPase Rab8 interacts with VAMP-3 to regulate the delivery of recycling T-cell receptors to the immune synapse. PMID: 26034069
- the role of Rabin8 (a mammalian ortholog of Sec2p) with Rab8-nucleotide-exchange factor activity in autophagy in mammalian cells, was examined. PMID: 25787272
- DLC3 is recruited to Rab8-positive membrane tubules and is required for the integrity of the Rab8 and Golgi compartments. PMID: 25673874
- Rab8A GTPase Ser(111) phosphorylation is not directly regulated by PINK1 in vitro and demonstrate in cells the time course of Ser(111) phosphorylation of Rab8A, 8B and 13 is markedly delayed compared to phosphorylation of Parkin at Ser(65). PMID: 26471730
- Intercellular transfer of transferrin receptor by a contact-, Rab8-dependent mechanism involving tunneling nanotubes. PMID: 26220176
- High expression of RAB8A is associated with endometrial cancer. PMID: 25477298
- Study established a direct interaction between alpha-synclein and Rab8a and provided unique insights into the molecular mechanisms of alpha-synclein toxicity PMID: 24983211
- Rab8a and Drebrin E act as key proteins in the regulation of apical trafficking in intestinal epithelial cells. PMID: 24399445
- Microvilli establishment required interaction between RAB8A and MYO5B, while loss of the interaction between RAB11A and MYO5B induced microvillus inclusions. PMID: 24892806
- TRIM required LAX for binding to Rab8 in a complex, a novel CTLA-4/TRIM/LAX/Rab8 effector complex in the transport of CTLA-4 to the surfaces of T cells PMID: 24515439
- Intermediates in the guanine nucleotide exchange reaction of Rab8 protein catalyzed by guanine nucleotide exchange factors Rabin8 and GRAB. PMID: 24072714
- Rab5a, Rab8a and Rab14 are major regulators of MT1-MMP trafficking and invasive migration of primary human macrophages. PMID: 23606746
- Fuzzy appears to control subcellular localization of the core PCP protein Dishevelled, recruiting it to Rab8-positive vesicles and to the basal body and cilium. We show that loss of Fuzzy results in inhibition of PCP signaling PMID: 23303251
- Slp4 and Rab8 are expressed and interact in human platelets, and might be involved in dense granule release. PMID: 23140275
- Optineurin acts as an adaptor to bring together Rab8 and its GTPase-activating protein TBC1D17. PMID: 22854040
- These findings show a role for Rab8a in the physiological function of hSVCT1 in intestinal epithelia. PMID: 23014846
- NDR2-mediated Rabin8 phosphorylation is crucial for ciliogenesis by triggering the switch in binding specificity of Rabin8 from PS to Sec15. PMID: 23435566
- This article reviewes biophysical and structural work and discuss possible functional implications of the finding that Rab8 binds with the highest affinity to OCRL1 among the Rab proteins tested.[review] PMID: 22790198
- These experiments provide us with an understanding of the role Rab8 plays in coordinated regulation of mGluR1a and how this impacts mGluR1a signaling PMID: 23175844
- Data suggest that the Rabin8-Rab8-Sec15 interaction may couple the activation of Rab8 to the recruitment of the Rab8 effector and is involved in the regulation of vesicular trafficking for primary cilium formation. PMID: 22433857
- EPI64 regulates membrane trafficking both by stabilizing Arf6-GTP and by inhibiting the recycling of membrane through the tubular endosome by decreasing Rab8a-GTP levels. PMID: 22219378
- This study demonistrated that Rabin8 regulates spine development. PMID: 22445341
- DCDC5 colocalizes with Rab8 and links it to dynein during cytokinesis. PMID: 22159412
- Rab8A function is not needed for budding or motility of exocytotic carriers but is required for their docking and fusion. PMID: 21596566
- WNK1 promotes cell surface expression of glucose transporter GLUT1 by regulating a Tre-2/USP6-BUB2-Cdc16 domain family member 4 (TBC1D4)-Rab8A complex PMID: 20937822
- RPGR modulates intracellular localization and function of RAB8A. PMID: 20631154
- Data provide strong evidence indicating that Rab8 GTPase interacts with distinct motifs in the C termini of alpha(2B)-AR and beta(2)-AR and differentially modulates their traffic from the TGN to the cell surface. PMID: 20424170
- Rab11, in its GTP-bound form, interacts with Rabin8 and kinetically stimulates the guanine nucleotide-exchange activity of Rabin8 toward Rab8. PMID: 20308558
- These findings establish Rab8 as a key component of the regulatory machinery that leads to ATP-binding cassette transporter A1 (ABCA1)-dependent removal of cholesterol from endocytic circuits. PMID: 17050734
- MT1-MMP delivery to invasive structures, and therefore its proinvasive activity, is regulated by Rab8 GTPase. PMID: 17332756
- Rab8a and Myosin Vb colocalize to a tubular network containing EHD1 and EHD3, which does not contain Rab11a. PMID: 17507647
- One microvillus inclusion disease patient who shows an identical phenotype to Rab8-deficient mice expresses a reduced amount of RAB8A PMID: 17597763
- Data show that the Rab8a, -17, and -23, and their cognate GTPase-activating proteins (GAPs), XM_037557, TBC1D7, and EVI5like, are involved in primary cilia formation, and that Rab8a specifically interacts with cenexin/ODF2. PMID: 17646400
- in response to cellular activation in T cells and B cells, a PTB-containing stability complex forms that contains binding sites for Rab8A and cyclin D(2) transcripts and increases their mRNA half-lifes PMID: 18714005
- data suggest that the function of Rab8 is important for DV2 infection, and Rab8 may be involved in DV2 infection. PMID: 18724065
- Both CEP290 and PCM-1 are required for ciliogenesis and are involved in the ciliary targeting of Rab8. PMID: 18772192
- Rab8 regulates ABCA1 cell surface expression and facilitates cholesterol efflux in primary human macrophages. PMID: 19304576
- These data suggest that Myo5c associated with Rab8 is involved in the release of dengue virus 2 from HepG2 cells. PMID: 19641326
顯示更多
收起更多
-
亞細胞定位:Cell membrane; Lipid-anchor; Cytoplasmic side. Golgi apparatus. Recycling endosome membrane. Cell projection, cilium. Cytoplasmic vesicle, phagosome. Cytoplasmic vesicle, phagosome membrane; Lipid-anchor; Cytoplasmic side. Cytoplasm, cytoskeleton, microtubule organizing center, centrosome, centriole. Cytoplasm, cytoskeleton, cilium basal body. Midbody. Cytoplasm. Cytoplasm, cytoskeleton, cilium axoneme.
-
蛋白家族:Small GTPase superfamily, Rab family
-
數據庫鏈接:
Most popular with customers
-
YWHAB Recombinant Monoclonal Antibody
Applications: ELISA, WB, IHC, IF, FC
Species Reactivity: Human, Mouse, Rat
-
Phospho-YAP1 (S127) Recombinant Monoclonal Antibody
Applications: ELISA, WB, IHC
Species Reactivity: Human
-
-
-
-
-
-